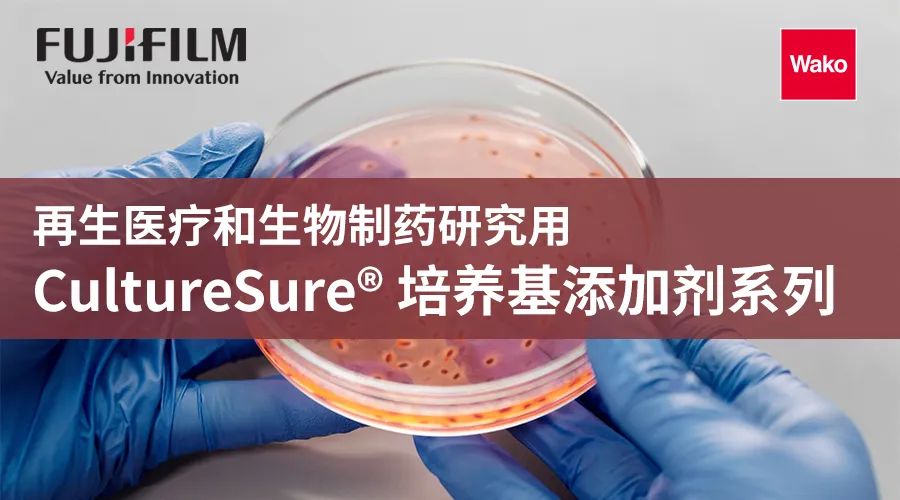

FUJIFILM Wako推荐使用CultureSure® 系列产品用于细胞培养。CultureSure® 系列中的培养基添加剂相关产品(氨基酸、维生素、糖、无机盐)无动物源性,并已通过内毒素、支原体、活菌数检测。
另外,CultureSure® 还实施了变更管理,是能够放心使用的培养基添加剂系列。
筑波大学生 命环境系1)、北海道大学 医学研究院 微生物学免疫学领域2)
浦山俊一1) 、福原崇介2)
◆前言
人类发现病毒的存在大约是在1900年,其契机是动植物间出现的一种原因不明的传染病。在寻找致病病原体的过程中,由于它比当时已知的最小病原体(微生物)更小,且具有异质性,因此被命名为"病毒"。此后,研究人员在所有生物体内都发现了各种不同类型的病毒,现在病毒被认为是细胞生物体内普遍存在的绝对寄生因子。
RNA病毒是以RNA为基因组的病毒的总称,从狭义上讲,是指去除在其生命周期内同时利用DNA的逆转录病毒(例如HIV的基因组是RNA,但它能经过逆转录进入宿主的基因组DNA中)的病毒群。它包含多种对人类,家畜和植物等经济型生物有重大危害的病毒,例如典型的SARS-CoV-2、流感病毒、寨卡病毒和丙型肝炎病毒。
对于肉眼无法看见且难以培养的RNA病毒,”发现”其存在至关重要。不仅是医疗领域,还需要更进一步展开关于这些RNA病毒的起源和传播的全健康(one health)研究,并从包含RNA病毒的全球生态系统的角度对其进行认识。因此,基于各种目的的RNA病毒检测方法也应运而生,本文将基于"双链RNA"的方法介绍其应用于高等动物组织的案例。
细胞培养方法种类繁多,例如,在培养皿上培养细胞,并集中分析同种细胞的单层静置培养法;通过搅拌培养基使细胞保持在悬浮状态进行培养的悬浮培养法;使用凝胶状基质进行培养的培养法等等。这些培养技术犹存已久,1962年,Boyden等人开发了细胞迁移分析法1),后被用于通过被称为细胞培养插件的培养基进行非接触式共培养法。1971年,立体培养细胞群开始有了“球体”2)的说法。
球体是指细胞通过相互粘附形成的简单集合体,并构建成三维结构的状态。顾名思义,「球(sphere)+oid」即指球状物体。一般而言,细胞会通过支架粘附于容器,若没有支架,或支架较弱时,就会相互粘附形成三维立体的结构。球体培养制备正是利用这一特点,不制作支架的方法。例如,使用非粘附性容器的制备方法;通过工学的微细加工技术使用结构体的方法;一边旋转培养器一边进行培养的旋转培养法;在液滴中进行立体构建的悬滴法等等3)。
关于进行共培养或球体培养的理由,若能让细胞与细胞间进行直接或是间接交流(相互作用),就能阐明细胞是否发挥了单个细胞无法发挥的功能。
球体与下述的类器官,虽然经常使用相同意思来表达,但球体的功能性并不如类器官发达,严格来说,两者间有着明显的区别。
类器官「器官(organ)+oid」,即指类似于器官的物体。一般而言,它指三维培养干细胞所得的组织。最近,由干细胞分化而成的不同种类的分化细胞,以及原分化细胞混合制备而成的立体细胞群也被称为类器官。因此,无论原始细胞是否皆为干细胞,均可广义地描述为“利用细胞技术人为制造与器官类似的组织”。生物学上类器官是指 “使用干细胞或有助于器官形成的前体细胞等,通过药物和环境构建等方法人为模拟胚胎学中的生物学过程,具有自律性形成的器官样集合体”。各项研究表明,类器官可详细再现人类器官的结构和生理功能,能够用于阐明病理和药物开发。为顺应临床测试周期的缩减以及动物实验替代的趋势,类器官的研究盛行。以生物学研究为基础,结合被称为organ-on-a-chip的工学技术进行培养和分析的研究盛行,总称为仿生系统(microphysiological systems:MPS)。美国环境部提出2025年将动物实验减少30%,2035年完全消除动物实验的计划。2023年1月6日,美国FDA颁布了临床试验前无需进行动物实验,可采用使用细胞技术实验结果的法案4)。虽然颁布的法案与预期相符,但依然让人震惊。某种意义上,两者间的关系正如“动物实验=汽油车”,“细胞技术和类器官=电动车”。换言之,未来使用细胞技术的新药研究将会成为主流,球体培养、Organ-on-a-chip 、MPS技术则会成为范式转移的关键技术。
为使水平链接细胞共培养板UniWells5)向Organ-on-a-chip/MPS系统进化,我们进行了开发。作为初级阶段的技术介绍,笔者将介绍水平方向连接的优点,以及运用其优点进行的球体和类器官的共培养。